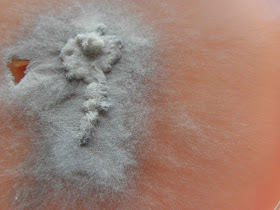

O fusarium oxysporum é um fungo filamentoso hialino. Estão descritos para esta espécie queratites, onicomicoses e infecções cutâneas disseminadas.
Este isolado refere-se a um caso de infecção cutânea em doente com patologia subjacente provocadora de imuodeficiência.
As colónias são de crescimento rápido ocupando em apenas alguns dias toda a placa de cultura. A textura é algodonosa ou flocosa e a cor varia de branco sujo a um cinza-púrpura. O reverso da colónia é cinza-púrpura escuro.
As características das colónias podem ser semelhantes às do Fusarium solanii.
Ao exame microscópico apresenta conidióforos com monofiálides curtas não septadas (diferente do F. solanii) inicialmene não ramificados; os macroconídeos são fusiformes, septados e ligeiramente curvos; os microconideos são abundantes e nunca em cadeias.
 |
| Colónia com 6 dias de incubação em gelose Sabouraud. |
 |
| Reverso da colónia. |
 |
| Colónia com 16 dias de incubação em gelose Sabouraud. |
 |
| Reverso da colónia. |
 |
| Conidióforos com monofiálides curtas não septadas (diferente do F. solanii) inicialmene não ramificados. |
 |
| Monofiálides curtas não septadas. |
 |
| Macroconideos fusiformes, septados e ligeiramente curvos
|
 |
| Microconideos são abundantes maioritariamente não-septados e nunca em cadeias.
|

Sem comentários:
Enviar um comentário